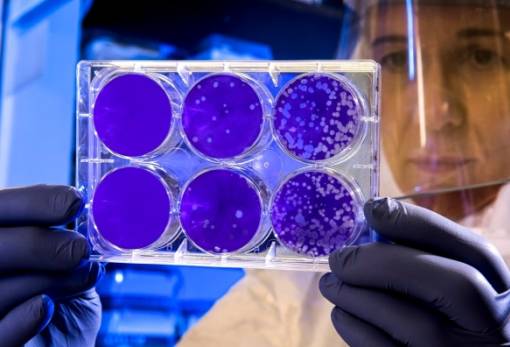
Το μίσος, η βασική αιτία των ανισοτήτων στην υγεία

ΕΠΙΣΤΗΜΗ
Ο πολυγραφότατος κ. Φωτόπουλος
Νέες εκδόσεις και μελέτες του Ηλείου Ιστορικού για την Πελοπόννησο εν όψει…
Πρόστιμα και εισαγωγές για ελλείψεις φαρμάκων
Παραγωγή καινοτόμων θεραπειών σε νοσοκομεία
Αποτελεσματικότητα στην αφαίρεση όγκων εγκεφάλου
Οι σύγχρονες τεχνικές που αλλάζουν τα δεδομένα
Καλός ύπνος: «κλειδί» για την υγεία και το βάρος
Πώς ο κακός ύπνος επηρεάζει μεταβολισμό, όρεξη και βάρος.
Πάσχα χωρίς κινδύνους για τα παιδιά
Οδηγός πρόληψης για ασφαλείς γιορτές από το Σωματείο «Αντιμετώπιση Παιδικού Τραύματος»
Γιατί τα μικρά παιδιά αρρωσταίνουν συνέχεια;
Τι είναι φυσιολογικό και πότε να ανησυχήσετε